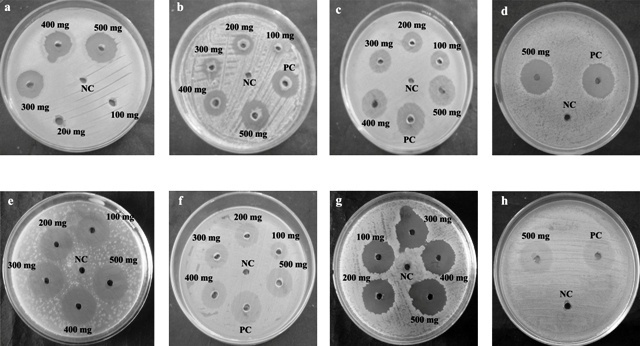

1Department of Biotechnology, Karpagam University, Pollachi Main Road, Coimbatore 641021, Tamil Nadu, India.
Email: teepica@gmail.com
Received: 05 Jan 2015 Revised and Accepted: 28 Jan 2015
ABSTRACT
Objective: To determine the phytochemical composition using spectral analysis and antibacterial activity of Limonia acidissima fruit methanol extract.
Methods: Phytochemical analysis was performed to determine the total alkaloids, saponins, total phenols and flavonoids content of fruit extract. Secondary metabolite compounds were determined performed by FT-IR and GC-MS analysis. Antibacterial activity assay was performed using agar well diffusion technique.
Results: The alkaloid and saponins contents of the crude methanol extract were found to be 38.47 g/100 g and 0.13 g/100 g dry matter respectively. The LF methanol extract showed total phenol contents of 33.38 µg/mg and the flavonoids was found to be 33.80 µg/mg extract. FT-IR analysis indicated the presence of phenols, alkanes, amino acids, α, β-unsaturated esters, alkenes, nitro compounds, aromatics, aliphatic amines, carboxylic acid, alkenes, and alkyl halides functional groups. The GC-MS analysis revealed the presence of linoleic acid, octadecanoic acid, hexadecanoic acid, maltol, vinly guaiacol, furanone, and ascorbic acid. The antibacterial activity assay showed dose dependent inhibition against clinical pathogens.
Conclusion: This study elucidated the prospective value of L. acidissima fruit as a nutritional and medicinal source.
Keywords: Limonia acidissima, Phytochemical, Bioactive compounds, FT-IR, GC-MS, Antibacterial activity.
INTRODUCTION
Microbial infections and their resistance to conventional therapy have become complicated. This phenomenon has prompted researchers to identify alternative medicines, for the prevention and effective treatment of infections. Plant extracts and biologically active compounds isolated from plants have gained widespread interest, as they have the property to cure a variety of diseases [1]. Medicinal plant compounds are widely accepted as they strengthen the immunity of the host and have minimal side effects. Over the years, the use of medicinal plants has grown consistently, with the population and the emergence of diseases caused by drug resistant pathogens [2, 3].
Limonia acidissima L. belongs to a monotypic genus Limonia and is classified under the family Rutaceae. It is an exotic deciduous tree found in India, Pakistan, Sri Lanka and Southeast Asia. The leaves, barks and roots of the plant have medicinal property and are used for diseases related to biological imbalance. The fruits of L. acidissima are well documented for its use in Indian traditional medicine and are commonly known as wood apple, elephant-apple, monkey fruit, vilampazham, kath bel and kaitha [4-6]. The fruits are spherical in shape with greyish-white rind and a woody hard outer shell. L. acidissima fruit pulp is sweet, sticky, brown, resinous, with peculiar aroma and consists of white seeds [7]. The raw fruit pulp is helpful in the treatment of gastro intestinal problems like flatulence, diarrhoea, dysentery and piles. The plant is reported to have adaptogenic activity against blood impurities, leucorrhoea, dyspepsia, and is used in case of snake bites, throat infections [8-10].
The fruit pulp is known for its medicinal importance in treating tumors, asthma, wounds, cardiac debility, hepatitis and insect stings [11]. Bioactive compounds such as coumarins, tyramine derivatives, tannins, flavonoids have been isolated from the fruit. Further, the plant is extensively studied for its significant anti-fungal [12], anti larvicidal activity [13], hepatoprotective [14], anti-inflammatory and anti-pyretic [15], antioxidant activity [6, 16]. Although the reports on medicinal properties of this plant are available, studies on the bioactive compounds of L. acidissima fruit and its efficacy against different pathogenic bacteria are still under explored. Our study focuses on the spectroscopic analysis to analyze the bioactive compounds present in L. acidissima fruit and determine the in vitro antibacterial activity against different clinical pathogens.
MATERIALS AND METHODS
Collection of plant material
Fruits were collected in the month of January, 2014 from the foot hills of Vellingiri, Coimbatore, Tamil Nadu, India. The plant material was taxonomically identified and authenticated (Voucher No. BSI/SC/5/23/09-10/Tech-319.) by Botanical Survey of India, Southern Circle, Tamil Nadu Agricultural University (Govt. of India), Coimbatore, Tamil Nadu, India. The fruits (L. acidissima) were thoroughly washed under tap water. The fruit pulp was separated mechanically from the rind and shade dried for a week, coarsely powdered using mixer grinder and stored in an air-tight container for further use.
Reagents
The reagents used for the study were of analytical grade as follows: Folin-Ciocalteu’s Phenol reagent (Himedia), Gallic Acid (Himedia), Dimethyl Sulphoxide (Loba Chemie), Aluminium chloride (Fisher), Sodium Hydroxide (Himedia), Ammonia solution (Himedia), Methanol (SD Fine), Ethanol, Catechin (Sigma-Aldrich), Sodium Chloride (Himedia), Di ethyl Ether (Loba Chemie), n-butanol (Himedia).
Solvent extraction
25 g of dried Limonia fruit (LF) pulp was extracted in 100 ml methanol (1:4) using cold percolation method. Supernatants were pooled and filtered through Whatmann filter paper No: 1 and evaporated using the rotary vacuum evaporator (Labomed, Model: R150). After evaporation of organic solvents, the extract yield was calculated and the extracts were stored at -20 ˚C till analysis.
Extract yield
The yield of dried extracts, based on their dry weights was calculated using the following equation:
Yield (g /100 g of dry plant material) = (W1 × 100) / W2
Where, W1 was the weight of the extract after the evaporation of solvent, and W2 was the weight of the dry plant material.
Estimation of alkaloids
Estimation of crude alkaloid was performed according to Harborne et al. (1973) [17]. About 5 g of LF powder was weighed and 100 ml of 10% acetic acid in ethanol was added and allowed to stand for 4 h. This solution was filtered and the extract was concentrated on a water bath to one part of the original volume. Concentrated ammonium hydroxide solution (15N) was added drop by drop to precipitate alkaloids in the solution.
The solution was allowed to settle, the precipitate was collected and washed with dilute ammonium hydroxide solution (5N) and filtered again. The resulting alkaloid was dried and weighed.
Estimation of saponins
Saponin content was determined by the method of Obadoni and Ochuiko, (2001) [18]. About 5 g of the LF powder was mixed with 30% aqueous ethanol. The sample was heated in a hot water bath at 55 °C for 4 h with continuous shaking. The mixture was filtered and the residue was re-extracted with 50 ml of 20% ethanol. Then the extract was reduced to three fourth of volume by heating in the water bath at 90 °C. The concentrate was transferred to a separating funnel and 20 ml of diethyl ether was added and shaken vigorously.
Then the aqueous layer was subjected to sequential purification process by adding 20 ml of n-butanol and washed with 15 ml of 10 % aqueous sodium chloride. The resulting solution was heated in a water bath. After evaporation the samples were dried in an oven to a constant weight and the saponin content was calculated in percentage.
Determination of total phenol content
Total phenol content was determined by using the Folin Ciocalteu’s reagent method [19]. Briefly, 100 µl of extract was mixed with 300 µl of Folin Ciocalteu’s reagent and kept at room temperature for 10 min. Then 1.5 ml of 20 % Sodium bicarbonate was added to the solution and incubated at room temperature for 3 h. After incubation absorbance of the sample was measured at 630 nm using a Shimamdzu-1610 UV-VIS spectrophotometer. A standard curve was plotted using different concentration of gallic acid and the amount of total phenol was calculated as gallic acid equivalents in μg /mg of dried extract.
Determination of total flavonoids
The total flavonoid content was determined by following the method of Chang et al. (2002), [20] with slight modifications. Briefly, 350 μl of sample was added to 4 ml of distilled water and mixed with 50 μl 5% NaNO2. The solution was incubated at 25 °C for 5 min and 30 μl of 10% AlCl3 was added, followed by 2 ml of 1M NaOH. The reaction mixture was then diluted with 10 ml distilled water and Optical density was measured at 510 nm. Catechin was used as standard and the results were expressed as catechin equivalents in µg/mg of dried extract.
Functional group analysis using FT-IR spectroscopy
The FT-IR spectra of L. acidissima fruit methanol extract was determined according to Sasidharan et al. (2011) [21]. FT-IR spectrophotometer (Perkin-Elmer 1725x) at the range 4000-400 cm-1 and resolution of 4 cm-1. The number of scan was 20.
Determination of bioactive compounds using GC-MS analysis
Bioactive compound analysis of LF methanol extract was determined by Shimadzu Gas chromatography (Model: QP2010 Plus, Japan), with a 30 m× 0.25 mm RTX-5MS low bleed column with a thickness of 0.25 µm. The carrier gas was helium and maintained at a column flow of 1.0 ml/min (at a pressure of 53.5 kPa). 1 µl of sample from a 100 mg/ml stocks was injected by split injection (1:20) at 260 °C.
The column temperature was maintained at 50 °C/3 min followed by temperature programming at 10 °C/min to 150 °C / 8 min. The temperature was further increased to 250 °C/ 2 min at the rate of 8 °C/min, and finally to 280 °C/5 min at a rate of 10 °C/min. The Mass Spectrometric Detector (MSD) was used in the ACQ Scan mode with an m/z ranging from 40-600 for the sample.
Screening of volatile and semi volatile compounds was performed using automatic screening software. The spectrum of the unknown components was compared with the spectrum of known components available in Wiley Online Library (Wiley08), NIST Chemistry Web book (NIST08) library. The compound name, molecular weight, and structure of the sample were determined.
Culture of pathogens
Clinical pathogens such as Staphylococcus aureus, Escherichia coli, Pseudomonas aeruginosa, Bacillus cereus, Vibrio cholerae, Klebsiella pneumoniae, Salmonella typhi, and Shigella dysentriae were obtained from Department of Microbiology, Karpagam University, Tamil Nadu, India. The cultures were maintained in glycerol stock at -20 °C for further use. Routine propagation of microbial cultures were carried out in Nutrient agar medium (Himedia, India).
Antibacterial activity assay
Antibacterial activity was performed by agar well diffusion assay, according to CLSI guidelines [22]. Briefly, 100 μl of the samples were added to the wells punctured on Muller Hinton Agar (Himedia, India) plates (MHA), that were uniformly pre-swabbed with test bacterial suspensions with the cell density equivalent to 0.5 McFarland standard (Himedia, India) units (1x108 cells/ml).
DMSO was used as Negative control and Ciprofloxacin (0.01 mg/ml) was used as antibiotic control. The plates were left undisturbed for 15 min for the absorption of excess moisture and then incubated at 37 °C for overnight. After incubation, the diameter (mm) of inhibitory zones were measured.
Statistical analysis
Data were subjected to statistical analysis using SPSS software (Version 21.0, USA). The values were expressed as mean ± S. E.
RESULTS AND DISCUSSION
Phytochemical analysis of Limonia acidissima fruit pulp
Phytochemical contents of the pulp Limonia fruit (LF) were determined and presented in table 1. The values of saponins and crude alkaloids were determined on dry weight basis (g/100 g). The methanol extract of LF showed an alkaloid content of about 38.47 g/100 g, while the saponins content was estimated to be 0.13 g/100g. Alkaloids have anaesthetic and spasmolytic activity, while saponins are reported to reduce the cholesterol level and enhance immunity [23]. The total phenol content was determined and the results were expressed in terms of standard µg gallic acid (GA) equivalent/mg of LF dry weight.
In our study, methanol extract of Limonia fruit showed total phenol content of 33.38 µg GA equivalent /mg of dry weight of fruit. Our results were slightly different from the observation of Shipra et al. (2014) [24] who, determined total phenol content in methanol extract of wood apple pulp. The total phenol contents may vary with different fruits due to some non-phenolic reducing compounds interfering with the phenol contents of the fruit [25].
Phenol compounds are associated with quality and nutritional value of fruit such as colour, taste, aroma and flavour. Further, phenol compounds are known to enhance the defence mechanism to neutralize reactive oxygen species and protect the plants from damage caused by microbes [26].
The present study showed the presence of flavonoids in LF fruit pulp of 33.80 µg catechin equivalent/mg of LF dry weight (table 1). Our results were in affirmation with Shipra et al. (2014) [24] who reported the total flavonoids content of Limonia fruit methanol extract as 35.71 µg/mg. Flavonoids were reported to have a wide range of biological activities such as anti-proliferative, enzyme inhibition, induction of apoptosis, antioxidant and antibacterial activity [27].
Table 1: Phytochemical composition and polyphenolic compounds of Limonia acidissima fruit methanol extract
| Component | Pulp |
| Yield percentage | 7.25 |
| Alkaloids* | 38.47 ±5.61 |
| Saponins* | 0.13 ±0.02 |
| Total Phenolsa | 33.38 ±0.20 |
| Flavonoidsb | 33.80 ±1.08 |
*Values are measured as g/100g of dry matter. aValues are measured as µg Gallic Acid/mg of sample. bValues are measured as µg Catechin/mg of sample. Except yield percentage, all values are expressed as mean ± S. E of triplicates.
FT-IR analysis of Limonia fruit pulp
The FTIR spectrum was performed to identify the functional group of the active components based on the peak value in the infra red radiation. The presence of intense bands at 2011.39 cm-1, 1725.98 cm-1, 1641.13 cm-1, 1517.70 cm-1, 1403.92 cm-1, 1225.54 cm-1, 1052.94 cm-1 corresponding to –C ≡C–/ C=O/C–O/ and N–O/ C–C/C–N with stretch/bend vibration respectively indicate the presence of alkynes, α, β-unsaturated esters, amino acids, nitro compounds, aromatic and aliphatic amines. The spectral range of 500-600 cm-1 indicated the presence of the compound with halides groups containing C–Br/C–Cl bond and stretching vibration. Very strong absorption spectra was observed at 779.101 cm-1, 816.706 cm-1, 865.882 cm-1, and 922.771 cm-1 corresponding to C-H/=C–H with bending vibrations which indicated the presence of aromatic and alkenes groups. The spectral peaks at 2928.38 cm-1, and 3397.96 cm-1 corresponds to functional groups C-H/ O–H/H with stretching vibration, which indicated the presence of amines, alcohols and phenols. Our results showed that the methanol extract of Limonia acidissima fruit contained alcohols, phenols, alkanes, amino acids, α, β-unsaturated esters, alkenes, nitro compounds, aromatics, aliphatic amines, carboxylic acid, alkenes, and alkyl halides compounds which showed major peaks as shown in fig. 1 and table 2.
The results indicated that the methanol extract of LF consist of amino acids which is evident from the strong absorption spectra observed at 1641.13 cm-1. Our results were in affirmation with our previous study which reported the presence of essential amino acids in wood apple fruit [6]. Moreover, the presence of α, β-unsaturated esters, functional group in the LF methanol extract indicated the presence of fatty acids which could be ascertained for its medical significance. There was no absorbance between the regions 2220-2260 cm-1 in the LF methanol extracts which indicated the absence of cyanide in the sample elucidating the absence of toxic substances in the fruit. This study corroborated with Sandhya et al. (2006) [28] who studied the functional group analysis of ethno medicinal plants for their medicinal properties. Further, the extract was found to contain compounds with amides, carboxylic acid, phenols, alcohol, and alkanes which serve as a significant pharmaceutical product for jaundice, fever and liver pain, treatment of throat infections, rheumatic joint pain, ulcer, and immune boosters [29].
Table 2: FT-IR absorption frequencies of functional groups in L. acidissima fruit methanol extract
| S. No. | Frequency (cm-1) | Bond and type of vibration* | Functional groups |
| 1 | 418.477 | unknown | - |
| 2 | 458.973 | unknown | - |
| 3 | 473.439 | unknown | - |
| 4 | 495.616 | unknown | - |
| 5 | 520.686 | C-Br (m), C-Cl stretch (m) | Alkyl halides |
| 6 | 539.007 | C-Br (m), C-Cl stretch (m) | Alkyl halides |
| 7 | 598.789 | C-Br (m), C-Cl stretch (m) | Alkyl halides |
| 8 | 779.101 | C-H (s), =C–H bend alkenes (s) | Aromatic, Alkenes |
| 9 | 816.706 | C-H (s), =C–H bend alkenes (s) | Aromatic, Alkenes |
| 10 | 865.882 | C-H (s), =C–H bend alkenes (s) | Aromatic, Alkenes |
| 11 | 922.771 | O-H bend | Carboxylic acid |
| 12 | 1052.94 | C-N stretch | Aliphatic amines |
| 13 | 1225.54 | C-N stretch | Aliphatic amines |
| 14 | 1403.92 | C–C stretch (in–ring) | Aromatic |
| 15 | 1517.70 | N-O stretch | Nitro compounds |
| 16 | 1641.13 | C–O stretch (m) | Amino acids |
| 17 | 1725.98 | C=O stretch | α, β-unsaturated esters |
| 18 | 2011.39 | –C ≡C– stretch | Alkynes |
| 19 | 2928.38 | C–H stretch | Amines |
| 20 | 3397.96 | O–H stretch, H–bonded (s,b) | Alcohols and Phenols |
*Bond strength; m-medium; s-strong; b-broad.

Fig. 1: Chromatogram showing the FT-IR Spectrum of L. acidissima fruit methanol (LA-Me) extract
Secondary metabolite analysis using GC-MS
The bioactive compounds of LF methanol extract were identified using GC-MS analysis and listed in fig. 2 and table 3. The results showed that the LF pulp contained many saturated fatty acids such as dodecanoic acid, tetradecanoic acid, penta decanoic acid, docosatrienoic acid. Fatty acids had been studied for their antioxidant, anticancer, anti-inflammatory and cardio protective properties. Further, dodecanoic acid was reported for the treatment of acne and increase HDL cholesterol. The present study showed the presence of ocatdecanoic acid (ɷ6 fatty acid) and hexadecanoic acid (ɷ3 fatty acid). Omega-3 and omega-6 fatty acids are poly unsaturated fatty acids synthesized by plants and reported to influence the metabolic, immunological and cardiovascular functions of host [30].
Dietary omega-3 fatty acids was found to exhibit anti cancer activity and increase the cytokine gene expression patterns in airway epithelial cells [31, 32]. According to Scorletti and Byrne (2013) [33], omega-3 fatty acids enhanced the lipid metabolism in liver and have positive effects on the fatty liver disease. The GC-MS analysis in this study showed the presence of Linoleic acid (ɷ6 fatty acid) in wood apple. Linoleic acid (LA) can modulate both innate and adaptive immunity [34]. Further, Omega-6 fatty acids showed significant development in foetal growth, particularly for the central nervous system, regulating visual acuity. Lack of essential fatty acids promotes skin inflammations and delays wound healing. Moreover, Omega-6 fatty acids was shown to inhibit proliferation of certain cancer cell lines in vitro and to reduce the progression of tumours in animals. Dietary supplementation of L. acidissima fruit was reported to increase immunoglobulin production in rat spleen lymphocytes and to reduce antigen-induced histamine and prostaglandin-2 release from sensitized guinea pig tracheae [35]. In addition, Linoleic acid was reported for antibacterial activity against different pathogens [36].
Our study showed the presence of Maltol and Vinyl guaiacol in the wood apple extract. Maltol [37], has characteristic sugary flavour and is used as flavour enhancer in candies and processed foods. Vinyl guaiacol is a phenolic substance present in plants and characterized by smoky, roasted flavour. It is used as a flavour enhancer in brewing and pharmaceutical industries [38]. Hunter et al. (2012) [39] studied the biotransformation of ferulic acid as substrates to green synthesize vinyl guaiacol. table 3 shows the presence of Furfural in the pulp which is a natural phenolic compound used in the production of drugs. Further, these furfural derivatives have been reported for their strong bactericidal activity and broad antibacterial spectrum [24, 40].
Table 3: GC-MS analysis of Limonia acidissima fruit methanol extract
| S. No. | Compound name | RT (min) | % area | CAS number |
| 1. | 2,5-Furandione, Dihydro-3-Methylene | 7.2 | 0.60 | 2170-03-8 |
| 2. | [3-(2,3-epoxypropoxy)propyl]ethoxydimethyl- Silane | 7.95 | 0.27 | 17963-04-1 |
| 3. | 2,3-Dihydro-3,5-Dihydroxy-6-Methyl-4H-Pyran-4-One | 10.8 | 0.33 | 28564-83-2 |
| 4. | Tetradecanoic acid | 25.42 | 0.11 | 544-63-8 |
| 5. | Pentadecanoic acid | 27.46 | 0.21 | 1002-84-2 |
| 6. | 9-Hexadecenoic Acid, Methyl Ester | 28.19 | 0.07 | 1120-25-8 |
| 7. | Hexadecanoic acid, methyl ester | 28.59 | 0.05 | 112-39-0 |
| 8. | 2-Hydroxycyclopentadecanone | 28.9 | 0.06 | 4727-18-8 |
| 9. | n-Hexadecanoic acid | 29.70 | 0.05 | 57-10-3 |
| 10. | Heptadecanoic acid, methyl ester | 30.11 | 0.07 | 1731-92-6 |
| 11. | l-(+)-Ascorbic acid 2,6-dihexadecanoate | 30.4 | 0.05 | 28474-90-0 |
| 12. | 2-Hydroxycyclopentadecanone | 30.47 | 0.35 | 4727-18-8 |
| 13. | n-Heptadecanoic acid | 30.72 | 0.24 | 506-12-17 |
| 14. | Linoleic acid, methyl ester | 31.1 | 0.11 | 112-63-0 |
| 15. | 8,11,14-Docosatrienoic acid, methyl ester | 31.22 | 0.17 | 56847-02-0 |
| 16. | Stearic acid, methyl ester | 31.5 | 2.58 | 112-61-8 |
| 17. | 9,12-Octadecadienoic acid (Z,Z) | 32.33 | 0.98 | 1577-52-2 |
| 18. | Octadecanoic acid | 32.55 | 20.92 | 57-11-4 |
| 19. | 1,13-Tetradecadien-3-One | 32.85 | 0.15 | 58879-40-6 |
| 20. | 9-Octadecenoic Acid, Methyl Ester | 33.62 | 0.39 | 112-62-9 |
| 21. | Eicosanoic acid, methyl ester | 33.91 | 0.32 | 1120-28-1 |
| 22. | 18-Nonadecenoic acid | 34.14 | 0.55 | 76998-87-3 |
| 23. | l-(+)-Ascorbic acid 2,6-dihexadecanoate | 34.41 | 2.99 | 2847490-0 |
| 24. | d-Ribose, 2-deoxy-bis(thioheptyl)-dithioacetal | 36.133 | 5.59 | 123390-22-7 |
| 25. | Hexadecanoic acid, 2-hydroxy-1-(hydroxymethyl)ethyl ester | 36.34 | 1.56 | 23470-00-0 |
| 26. | Docosanoic Acid, Methyl ester | 36.55 | 49.23 | 929-77-1 |
| 27. | 9,12-Octadecadienoic acid (Z,Z)-, trimethylsilyl ester | 38.18 | 7.27 | 56259-07-5 |
| 28. | 9-Octadecenoic acid (Z)-, 2,3-dihydroxypropyl ester | 38.46 | 0.40 | 2716-53-2 |
| 29. | 9,12,15-Octadecatrienoic acid, ethyl ester, (Z,Z,Z) | 38.52 | 0.15 | 1191-41-9 |
| 30. | Octadecanoic acid, 2,3-dihydroxypropyl ester | 38.7 | 0.30 | 123-94-4 |
| 31. | 1,2,3-Propanetriol | 9.44 | 0.51 | 56-81-5 |
| 32. | Maltol | 9.75 | 0.66 | 118-71-8 |
| 33. | 2-Furancarboxaldehyde, 5-(hydroxymethyl)- | 12.15 | 0.11 | 67-47-0 |
| 34. | 5-(Hydroxymethyl)-2-(dimethoxymethyl)furan | 13.02 | 0.33 | 90200-14-19 |
| 35. | 2-Methoxy-4-Vinylphenol (Vinylguaiacol) | 13.33 | 0.12 | 7786-61-0 |
| 36. | 3-Furanacetic acid, 4-Hexyl-2,5-Dihydro-2,5-Dioxo | 16.62 | 0.21 | 39212-21-0 |
| 37. | Dodecanoic Acid | 18.8 | 0.92 | 143-07-7 |
| 38. | 3',5'-Dimethoxyacetophenone | 19.05 | 0.80 | 39151-19-4 |
| 39. | Quinic acid | 21.17 | 0.21 | 77-95-2 |
RT- Retention time; CAS Number- Chemical Abstract Services number
Antibacterial activity test
The antibacterial efficacy of Limonia acidissima fruit methanol extract, against different bacterial pathogens was determined using the agar well diffusion assay (fig. 3; table 4). The assay was performed against gram positive (S. aureus and B. cereus) and gram negative (E. coli, P. aeruginosa, S. typhi, S. dysentriae, V. cholerae and K. pneumoniae) at varying concentration (100 to 500 mg/ml). The present study showed that the inhibition of pathogens was dose dependent and highest inhibition was observed in 500 mg/ml concentration.
However, the antibacterial efficacy of LF extract was similar at the tested concentrations (100 mg/ml to 500 mg/ml) against S. typhi and V. cholerae.

Fig. 2: Chromatogram showing the GC-MS spectrum of L. acidissima fruit methanol (LA-Me) extract
In contrast the LF methanol extract did not show inhibition against B. cereus at lower concentrations. Patil et al. (2012) [41] observed significant antibacterial activity of Limonia fruit pulp as compared to leaves and bark against bacterial pathogens. Our findings corroborates with Shipra et al. (2014) [24] who, evaluated the antibacterial efficacy of wood apple methanol extract against bacterial pathogens. According to the results obtained in this study, the antimicrobial effects of the extract and observed differences may be due to compounds such as phenolics [42]. On the other hand, total phenolic content determined by Folin-Ciocalteu method is not an absolute measurement of the amount of phenolic materials. In the present study the methanol extract of wood apple fruit showed a highest zone of inhibition against Salmonella typhi (27 mm) whereas the fruit extract exhibited lowest inhibition zone against Bacillus cereus (19.3 mm) which elucidated that antibacterial vary with different pathogens. The difference in antibacterial activity may be attributed to the bioactive components present in fruit such as phenolics and fatty acids exhibiting varying degree of activity against pathogens [6, 24]. According to Sun et al. (2003) [43], fatty acids have the potential to inhibit the enteric pathogens. Jae-Suk Choi et al. (2013) [44] elucidated the significant inhibitory effect of unsaturated fatty acids against the oral pathogens. The GC/MS screening confirmed the presence of omega-3 and omega-6 fatty and so it could be reasonably argued that these factors might be contributing towards the antimicrobial property of Limonia acidissima fruit.
Table 4: Antibacterial activity of L. acidissima fruit methanol extract against bacterial pathogens
Name of the bacteria |
Zone of inhibition (mm)* |
|
LA-Me |
PC |
|
S. aureus |
21.6 ±0.23 |
25.1 ±0.60 |
B. cereus |
19.3 ±0.40 |
28.4 ±0.45 |
E. coli |
25.6 ±0.55 |
26.7 ±0.30 |
S. typhi |
27.0 ±0.70 |
29.7 ±0.54 |
S. dysentriae |
22.6 ±0.44 |
26.8 ±0.76 |
K. pneumoniae |
24.4 ±0.24 |
25.8 ±0.44 |
V. cholerae |
20.4 ±0.45 |
29.5 ±0.80 |
P. aeruginosa |
24.5 ±0.34 |
26.1 ±0.70 |
*LA-Me: Limonia fruit methanol extract; PC: Positive Control (Ciprofloxacin — 0.01 mg/ml). Values are expressed as mean ± S. E of triplicates.
Fig. 3: Effect of Limonia acidissima fruit methanol extract against different clinical pathogens at tested concentrations (100 mg/ml to 500 mg/ml). a) Bacillus cereus, b) Escherichia coli, c) Pseudomonas aeruginosa, d) Staphylococcus aureus, e) Salmonella typhi, f) Shigella dysentriae, g) Vibrio cholerae, h) Klebsiella pneumoniae. PC- Positive control: Ciprofloxacin (0.01 mg/ml), NC- Negative control (DMSO).
CONCLUSION
In conclusion, phytochemical and spectral analysis of Limonia fruit methanol extract confirms the presence of secondary metabolites, helpful in treatment of a variety of illness. The antibacterial activity elucidates that the fruit could be used as an alternative source for treatment against antibiotic resistant pathogens. Our findings substantiate the nutraceutical application of wood apple as it is a rich source of bioactive components. Wood apple fruit could be considered as a potential source for antibacterial drug development. The purification and structural elucidation of the anti microbial compound present in the fruit are under investigation.
ACKNOWLEDGEMENT
The financial support provided by the Department of Science and Technology, Science and Engineering Research Board, Ministry of science and technology, Government of India (Ref. No. DST-SERB/FT/LS-128/2012) is gratefully acknowledged. The authors thank Karpagam University, Tamil Nadu, India for providing the infrastructure facility.
CONFLICT OF INTERESTS
Declared None
REFERENCES